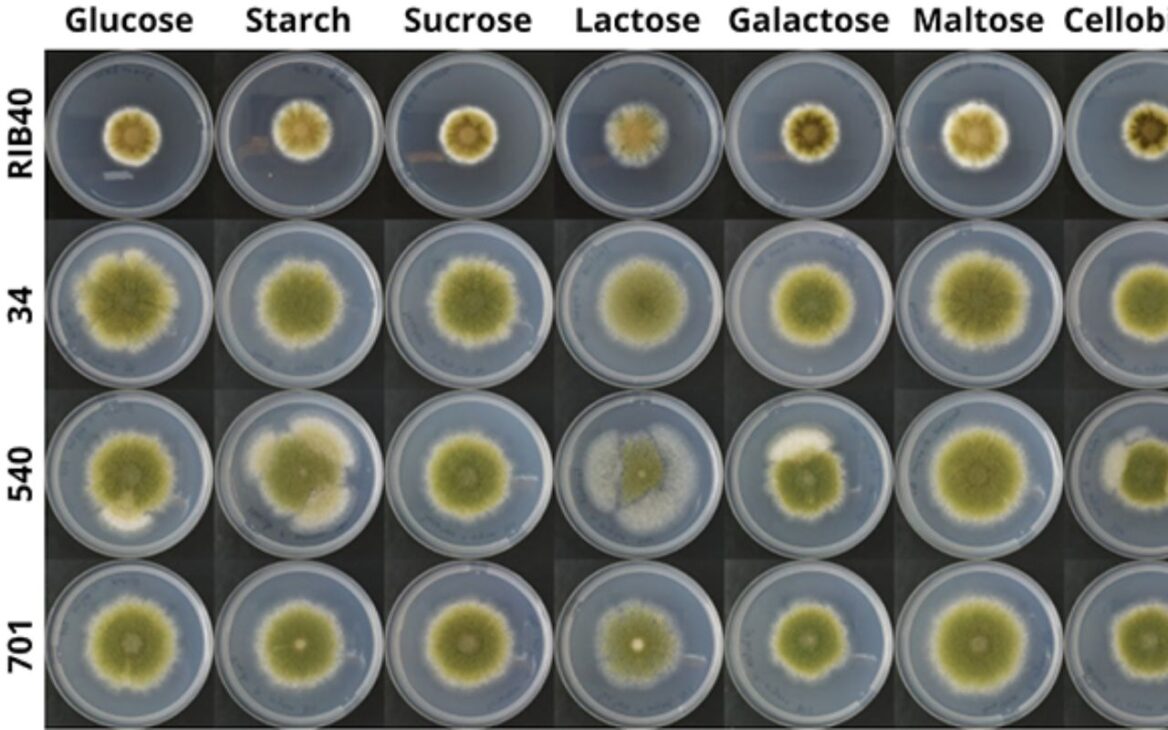

La proteína hecha de hongos que imita carne debe superar US$ 32 mil millones hasta 2032. Micoproteínas ganan espacio como alternativa sostenible a las proteínas animales.
La proteína hecha de hongos, capaz de imitar carne en textura, apariencia y aplicación culinaria, debe mover más de US$ 32 mil millones hasta 2032, según datos divulgados por Embrapa.
El crecimiento del sector es impulsado por avances en biotecnología, fermentación de precisión e ingeniería genética, además de la búsqueda global por fuentes de proteína más sostenibles.
El cambio involucra investigadores, universidades y empresas de alimentos en diferentes países y surge como respuesta directa a los desafíos ambientales y a la presión sobre los sistemas tradicionales de producción de carne.
-
A partir del 7 de junio, 27 países europeos prohíben la pregunta sobre el salario anterior en entrevistas y Brasil ha elegido un camino diferente.
-
La multimillonaria Anne Marie Werninghaus, heredera de WEG con R$ 9,1 mil millones, inauguró la tienda a.marie en el Casarão Emmendörfer, en Jaraguá do Sul.
-
Enquanto milhões de brasileños aún enfrentan desempleo y salarios bajos, empresas chinas amplían la contratación de extranjeros, llevan a más de mil chinos por mes a Brasil y cambian la realidad industrial de Bahía.
-
China está a punto de poner sus manos en una de las mayores fuentes de níquel de Brasil, pero la Unión Europea decidió detener la negociación de US$ 500 millones y podría incluso bloquear la venta definitivamente en los próximos meses.
El movimiento no pretende sustituir totalmente las proteínas animales, sino ampliar el abanico de opciones alimentarias.
La estrategia combina innovación tecnológica, reducción de impacto ambiental y diversificación de las dietas, en un momento en que la seguridad alimentaria y la sostenibilidad se han convertido en temas centrales en el debate global.
¿Cómo se produce la proteína de hongos que imita carne?
La base de esta innovación está en el micelio, estructura responsable por el crecimiento de los hongos.
A través de la fermentación de precisión, este material se cultiva en un ambiente controlado y se transforma en micoproteínas con alto valor nutricional.
Según André Damasio, investigador y profesor de la Universidad Estatal de Campinas (Unicamp), los hongos filamentosos y las levaduras han pasado a funcionar como verdaderas “fábricas celulares”.
“La producción de micoproteínas se destaca por exigir menos tierra y agua, y emitir menos gases de efecto invernadero que la ganadería convencional”, explica.
Además, el proceso permite mayor previsibilidad productiva, menor dependencia del clima y reducción de riesgos asociados a la cría intensiva de animales.
¿Por qué crece tan rápido la proteína de hongos que imita carne?
El avance de la proteína de hongos que imita carne ocurre porque atiende a múltiples demandas al mismo tiempo.
Desde el punto de vista ambiental, el sistema reduce emisiones y uso de recursos naturales.
En el aspecto económico, permite producción en escala industrial con costos más controlables.
De acuerdo con Embrapa, este tipo de proteína presenta contenido proteico entre 45% y 48% y alto contenido de fibras, que varía de 22% a 35%. Además, posee sabor neutro, lo que facilita su aplicación en diferentes productos.
Estas características explican por qué grandes empresas alimenticias han estado invirtiendo en análogos de carne y productos híbridos, que combinan proteína animal, vegetal y micelio.

Aspectos nutricionales de las micoproteínas
Desde el punto de vista nutricional, las micoproteínas ofrecen aminoácidos esenciales, además de minerales como zinc y selenio.
Estudios clínicos indican beneficios como mayor saciedad, ayuda en el control glicémico y reducción del colesterol.
Por otro lado, especialistas advierten que estas proteínas no contienen vitamina B12 ni hierro, nutrientes normalmente asociados a la carne.
Por eso, deben integrarse de forma equilibrada en la dieta, especialmente cuando se utilizan como principal fuente proteica.
Aún así, investigaciones iniciales apuntan a un potencial incluso para estimular la síntesis de proteína muscular, lo que amplía el interés del sector deportivo y funcional.
La proteína de hongos que imita carne no quiere eliminar la ganadería
Para Paula Cunha, investigadora de Unicamp, el crecimiento de este mercado no representa una amenaza directa a la carne animal.
Según ella, la propuesta es complementar el sistema alimentario, ofreciendo alternativas viables que reduzcan la presión ambiental de la producción intensiva.
Al diversificar las fuentes de proteína, el sistema se vuelve más resiliente frente a los cambios climáticos, a la escasez de recursos naturales y al aumento de la población global.
Desafíos técnicos y regulatorios aún limitan el avance
A pesar del potencial económico, la proteína de hongos que imita carne aún enfrenta desafíos importantes.
Uno de ellos está en la estandarización de las propiedades del micelio, como textura, sabor y funcionalidad en diferentes aplicaciones industriales.
En el ámbito regulatorio, Gabriel Mascarin, ingeniero agrónomo de Embrapa Medio Ambiente, destaca la necesidad de más estudios clínicos.
“Faltan datos sobre biodisponibilidad de aminoácidos, efectos a largo plazo en la salud y parámetros claros de seguridad alimentaria”, afirma.
También hay preocupación por la presencia de toxinas y metales pesados, lo que exige normas rigurosas, especialmente debido a la variedad de sustratos utilizados en la fermentación.
Mercado billonario y papel estratégico en el futuro de la alimentación
Productos a base de micoproteínas son clasificados como “nuevos alimentos” y pasan por evaluaciones rigurosas antes de la liberación comercial.
Aunque aprobados en Estados Unidos desde 2001, aún no existen directrices específicas para el consumo diario.
Aun así, la proyección de más de US$ 32 mil millones hasta 2032 indica que la proteína hecha de hongos que imita carne tiende a ocupar un lugar fijo en las estanterías y en los hábitos alimentarios.
Entre innovación, sostenibilidad y nutrición, los hongos dejan de ser coadyuvantes y asumen protagonismo en el futuro de la alimentación global.
Con información de AgroEstadão

 Portugués
Portugués  Inglés
Inglés  Español
Español 











-

-

7 personas reaccionaron a esto.